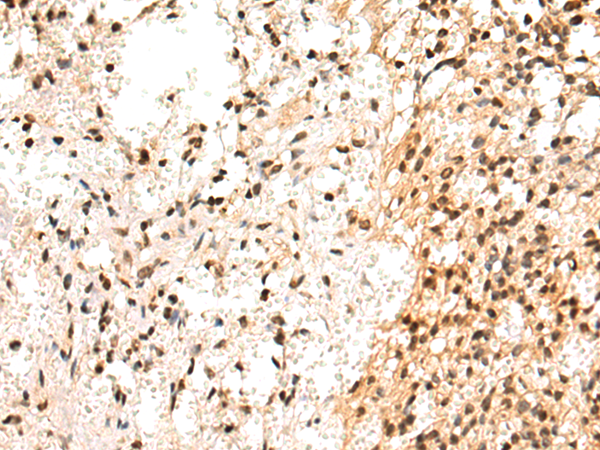

|
Background: |
The nuclear body is a multiprotein complex that may have a role in the regulation of gene transcription. This gene is a member of the SP100/SP140 family of nuclear body proteins and encodes a leukocyte-specific nuclear body component. The protein can function as an activator of gene transcription and may serve as a nuclear hormone receptor coactivator. In addition, it has been suggested that the protein may play a role in ribosome biogenesis and in the induction of myeloid cell differentiation. Alternative splicing has been observed for this gene and three transcript variants, encoding distinct isoforms, have been identified. |
|
Applications: |
ELISA, WB, IHC |
|
Name of antibody: |
SP110 |
|
Immunogen: |
Fusion protein of human SP110 |
|
Full name: |
SP110 nuclear body protein |
|
Synonyms: |
IPR1; VODI; IFI41; IFI75 |
|
SwissProt: |
Q9HB58 |
|
ELISA Recommended dilution: |
5000-10000 |
|
IHC positive control: |
Human breast cancer and Human prostate cancer |
|
IHC Recommend dilution: |
50-200 |
|
WB Predicted band size: |
78 kDa |
|
WB Positive control: |
LOVO cell lysate |
|
WB Recommended dilution: |
500-2000 |

購(gòu)物車(chē)
幫助
021-54845833/15800441009
